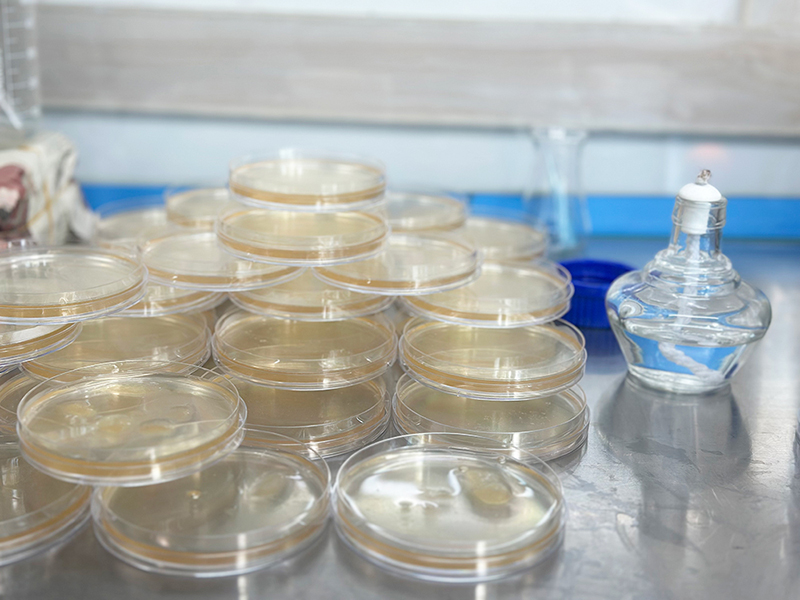
微信圖片_2025-07-16_174312_672.jpg

盛夏鹽都,青春與產(chǎn)業(yè)碰撞的火花
2025年8月9日,民盟盟員、成都大學(xué)食品與生物工程學(xué)院趙志平博士和四川旅游學(xué)院川酒川菜研究院院長聶鑫博士帶領(lǐng)的碩士研究生團(tuán)隊(duì),在為期一個月的深度實(shí)習(xí)與科技幫扶中圓滿落幕。


這群年輕的科研力量深入生產(chǎn)一線,將實(shí)驗(yàn)室的前沿知識與泰福的產(chǎn)業(yè)實(shí)踐深度融合,為大頭菜傳統(tǒng)工藝的科技化升級注入強(qiáng)勁動能,也為企業(yè)創(chuàng)新鏈條增添了鮮活血液。


研究生團(tuán)隊(duì)全程跟進(jìn)原料處理、發(fā)酵調(diào)控、產(chǎn)品檢驗(yàn)等環(huán)節(jié),重點(diǎn)記錄鹽度梯度控制點(diǎn)、微生物采樣。通過實(shí)時監(jiān)測設(shè)備和人工采樣結(jié)合,構(gòu)建了完整的生產(chǎn)數(shù)據(jù)鏈,探索其健康屬性與商業(yè)化潛力,推動產(chǎn)品向功能化、高附加值方向升級。

作為省級農(nóng)業(yè)產(chǎn)業(yè)化重點(diǎn)龍頭企業(yè),泰福始終將人才視為創(chuàng)新的第一資源。正如泰福負(fù)責(zé)人羅淮良所言:“青年才俊的加入,不僅為企業(yè)注入了新鮮血液,更讓我們看到了傳統(tǒng)產(chǎn)業(yè)與現(xiàn)代科技碰撞出的無限可能。”


當(dāng)青春智慧碰撞匠心沃土,一粒芥菜種子正孕育產(chǎn)業(yè)新生態(tài)。泰福與高校的“雙向奔赴”,是技術(shù)的嫁接、人才的孵化,更是傳統(tǒng)產(chǎn)業(yè)借科技突破轉(zhuǎn)型的生動實(shí)踐。未來,這片深耕不輟的產(chǎn)學(xué)研沃土,必將釀造更醇香的發(fā)展新篇!